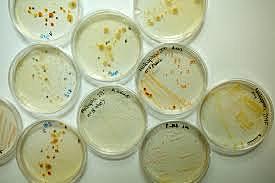
Técnicas de Julius Brefeld

-
Primeras apariciones de tizón en los cultivos de cereales y legumbres.
-
El filósofo griego da su primera opinión de cómo controlar el tizón en los cultivos de cereales.
-
Descubren que las esporas causan un hongo en el cultivo de trigo.
-
Hallazgo del tipo A2 de tizón tardío en la papa.
-
Permitieron mejorar los estudios de la genética de poblaciones del tizón tardío de la papa que nos permitieron conocer los peligros para la producción de papa que ocurrían después de los procesos de variación genética del patógeno.
-
Este botánico desarrollo técnicas con cultivos de microorganismos que consiste en proporcionar a los microorganismos las condiciones físicas, químicas y nutritivas necesarias para que puedan realizar su actividad fisiológica y reproductiva de forma controlada.
-
Adolf Mayer hizo el descubrimiento e hizo su descripción inicial.
-
No fue hasta 1930 que el mosaico del tabaco fue reconocido como virus y que no se transmitia por bacterias.
-
Se identificó que los hongos no son los causantes de algunas enfermedades en las plantas si no que son causadas por distintas toxinas liberadas por bacterias.
-
En este año se creó la primera planta genéticamente modificada, una planta de tabaco a la cual se añadió a su genoma un gen de resistencia para el antibiótico Kanamicina.
Want to make a timeline like this?
Use Timetoast to turn dates, events, milestones, and phases into a clear visual timeline you can build and share. Timetoast is a timeline maker for work, school, research, and stories.